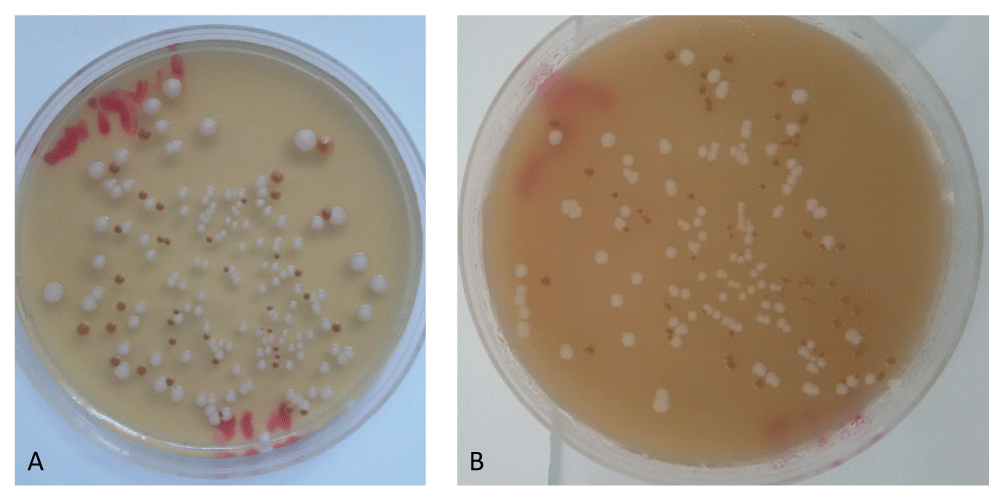

Figure 2
Evaluation of novel culture media prepared from plant substrates for isolation and identification of Cryptococcus Neoformans Species Complex
Ellabib M*, Krema ZA, Mokthar ES, El Magrahi HS, Eshwika A and Cogliati M
Published: 14 August, 2018 | Volume 1 - Issue 1 | Pages: 009-013
Figure 2:
Cryptococcus neoformans species complex isolated from pigeon dropping samples as brown-pigmented colonies and Candida albicans as white colonies. A) Pumpkin seed agar medium; B) lupine seed agar medium.
Read Full Article HTML DOI: 10.29328/journal.ijcmbt.1001002 Cite this Article Read Full Article PDF
More Images
Similar Articles
-
Evaluation of novel culture media prepared from plant substrates for isolation and identification of Cryptococcus Neoformans Species ComplexEllabib M*,Krema ZA,Mokthar ES,El Magrahi HS,Eshwika A,Cogliati M. Evaluation of novel culture media prepared from plant substrates for isolation and identification of Cryptococcus Neoformans Species Complex. . 2018 doi: 10.29328/journal.ijcmbt.1001002; 1: 009-013
Recently Viewed
-
Foam Sclerotherapy versus surgery in treatment of chronic venous diseaseFatih Islamoglu*. Foam Sclerotherapy versus surgery in treatment of chronic venous disease. Arch Vas Med. 2020: doi: 10.29328/journal.avm.1001011; 4: 005-007
-
One-time CRISPR Adenine Base Editing Intervention in SMA: From SMN2 Splice Correction to Motor Neuron RescueSheena P Kochumon,Najma Nujoom,Prem Jagadeesan,Vinod Scaria,DM Vasudevan,KP Soman,Cherupally Krishnan Krishnan Nair*. One-time CRISPR Adenine Base Editing Intervention in SMA: From SMN2 Splice Correction to Motor Neuron Rescue. J Genet Med Gene Ther. 2026: doi: 10.29328/journal.jgmgt.1001014; 9: 1-6
-
Application of In vitro Reconstructed 3D Biomimetic Tumor Microenvironment Models in Cancer ResearchYinuo Ma,Zhiyuan Lu,Yili Sun,Jia Li. Application of In vitro Reconstructed 3D Biomimetic Tumor Microenvironment Models in Cancer Research. Arch Cancer Sci Ther. 2026: doi: 10.29328/journal.acst.1001051; 10: 16-27
-
Management and Therapeutic Strategies for Spinal Muscular AtrophySheena P Kochumon, Cherupally Krishnan Krishnan Nair*. Management and Therapeutic Strategies for Spinal Muscular Atrophy. J Genet Med Gene Ther. 2024: doi: 10.29328/journal.jgmgt.1001009; 7: 001-007
-
A Critical Review on Some Recent Developments in Comparison of Biological SequencesDK Bhattacharya*. A Critical Review on Some Recent Developments in Comparison of Biological Sequences. J Genet Med Gene Ther. 2024: doi: 10.29328/journal.jgmgt.1001010; 7: 008-014
Most Viewed
-
Physical Performance in the Overweight/Obesity Children Evaluation and RehabilitationCristina Popescu, Mircea-Sebastian Șerbănescu, Gigi Calin*, Magdalena Rodica Trăistaru. Physical Performance in the Overweight/Obesity Children Evaluation and Rehabilitation. Ann Clin Endocrinol Metabol. 2024 doi: 10.29328/journal.acem.1001030; 8: 004-012
-
Hypercalcaemic Crisis Associated with Hyperthyroidism: A Rare and Challenging PresentationKarthik Baburaj*, Priya Thottiyil Nair, Abeed Hussain, Vimal MV. Hypercalcaemic Crisis Associated with Hyperthyroidism: A Rare and Challenging Presentation. Ann Clin Endocrinol Metabol. 2024 doi: 10.29328/journal.acem.1001029; 8: 001-003
-
Effects of dietary supplementation on progression to type 2 diabetes in subjects with prediabetes: a single center randomized double-blind placebo-controlled trialSathit Niramitmahapanya*,Preeyapat Chattieng,Tiersidh Nasomphan,Korbtham Sathirakul. Effects of dietary supplementation on progression to type 2 diabetes in subjects with prediabetes: a single center randomized double-blind placebo-controlled trial. Ann Clin Endocrinol Metabol. 2023 doi: 10.29328/journal.acem.1001026; 7: 00-007
-
Exceptional cancer responders: A zone-to-goDaniel Gandia,Cecilia Suárez*. Exceptional cancer responders: A zone-to-go. Arch Cancer Sci Ther. 2023 doi: 10.29328/journal.acst.1001033; 7: 001-002
-
Ectopic adrenal tissue at the spermatic cordAbdallah Chaachou,Nizar Cherni,Wael Ferjaoui*,Mohamed Dridi,Samir Ghozzi. Ectopic adrenal tissue at the spermatic cord. J Clin Med Exp Images. 2022 doi: 10.29328/journal.jcmei.1001024; 6: 001-002

If you are already a member of our network and need to keep track of any developments regarding a question you have already submitted, click "take me to my Query."



















































































































































